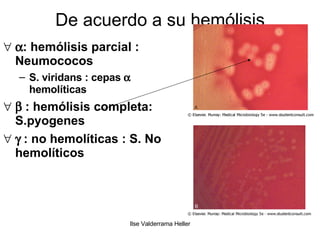
De acuerdo a su hemólisis  : hemólisis parcial : Neumococos S. viridans : cepas    hemolíticas    : hemólisis completa: S.pyogenes    : no hemolíticas : S. No hemolíticos

Los estreptococos son cocos Gram positivos que incluyen varias especies patógenas para humanos como S. pyogenes, S. agalactiae y S. pneumoniae. Se clasifican según su patrón de hemólisis, serogrupo y características bioquímicas. S. pyogenes causa faringitis estreptocócica y enfermedades supurativas y no supurativas como escarlatina y fiebre reumática. S. agalactiae coloniza el tracto genital y puede causar sepsis neonatal. S. pneumoniae es un